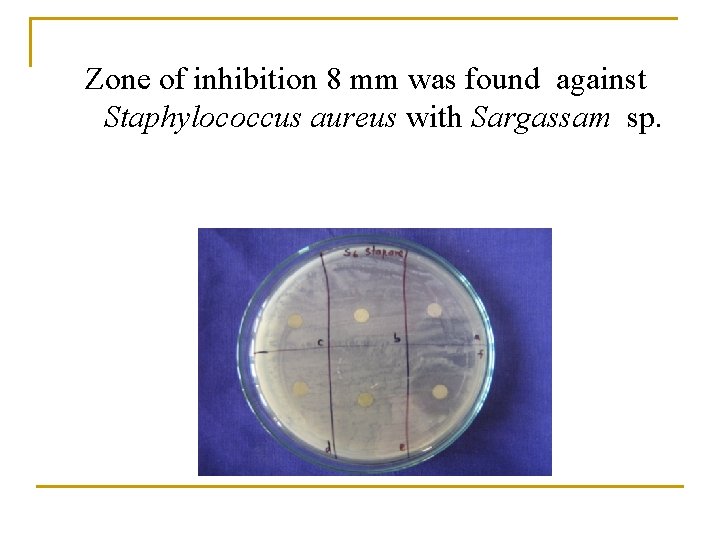

Exploration and Purification of Bioactive compound from seaweeds

Exploration and Purification of Bioactive compound from seaweeds against human bacterial pathogen

INTRODUCTION v v Most pathogenic bacteria becoming resistant to drugs, due to indiscriminate use of antibiotics. It becomes a greater problem of giving treatment against resistant pathogenic Seaweeds are macrophytic algae, a primitive type of plants lacking true roots, stems and leaves. Seaweeds are considered as the source of bioactive compounds which act against both gram positive and gram negative pathogenic bacteria.

Aim of the work n Screening of seaweed extract which posses bioactivity against human pathogens. n To isolate and purify the compounds from seaweed extract using silica column chromatography. n To analyze the bioactivity of isolated pure compound. n To identify the bioactive compound by Mass spectroscopy and NMR.

MATERIALS AND METHODS

n Seaweeds were collected from Leepuram, Kootapuli coastal area, Kanyakumari district. n The seaweeds collected were identified and washed with tap water followed by distilled water and air dry under shady place for two weeks. n Dried seaweeds are ground to 2 mm or smaller particle size. n 1 g of each seaweed powder are mixed with solvents in shaker for 10 minutes. (methanol, chloroform, ethyl acetate and hexane).

n The crude extract thus obtained was screened for its bioactivity using the standard disc diffusion method. n Incubated at 320 c for 24 hours. n Formation of zone of inhibition indicate the antimicrobial activity of the particular extract. n The zone between 7 to 8 mm is excellent , 6 to 7 is good , less than that as poor.

n Purification of bioactive compounds - silica column chromatography and Thin layer chromatography. n Pure compound is obtained anaylzed for its bioactivity. n Pure bioactive compound was identified in Mass spectroscopy and NMR.

RESULTS

n The seaweeds collected were Amphiroa foliaceae, Chactomorpho tortuosa, Caulerpa scalpelliforms and Sargassum sp. n The bioactivity of seaweed extracts were determined against Klebsilla sp, Staphylococcus aureus and proteus sp. n The zone of inhibition was found in the Amphiroa foliacea in solvent hexane and Sargassam sp in the solvent ethyl acetate against Proteus sp, Staphylococcus
Zone of inhibition 8 mm was found against Staphylococcus aureus with Sargassam sp.

n The crude extract of Sargassam sp was selected for purification of bioactive compound by Silica column chromatography. n The fraction 4 possessed a single compound in TLC. n The single compound fraction 4 was analyzed for its bioactivity. n A zone of inhibition about 7 mm was found against Staphylococcus aureus

TLC of fraction 4 Antibacterial activity of fraction 4

ESIMS profile MS/MS spectra of m/z 279 of Fraction 4


Future work n Research on Αlpha hydroxy stearic acid could be carried out as lead compound against the pathogen Staphylococcus aureus

Thank You
- Slides: 16